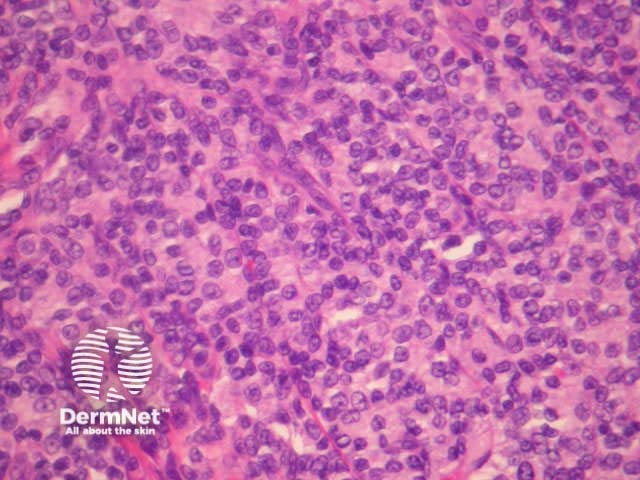
Figure 4

Main menu
Common skin conditions
NEWS
Join DermNet PRO
Read more
Quick links
Lesions (cancerous) Diagnosis and testing
Author: Assoc Prof Patrick Emanuel, Dermatopathologist, Auckland, New Zealand. January 2015.
Indolent cutaneous CD8+ lymphoid proliferation is a recently described rare entity among cutaneous T-cell lymphomas that typically presents with solitary skin lesions on the face or at acral sites.
Histologically, indolent CD8+ lymphoid proliferations are characterised by a dense dermal infiltrate of non-epidermotropic, medium sized pleomorphic lymphocytes. These form a dense mass in the dermis and may involve subcutaneous tissues (figures 1-5).

Figure 1

Figure 2

Figure 3
Figure 4

Figure 5

Figure 6
The T-cells stain with CD3 and CD8 (figure 6). There is minimal staining with CD4. Other T-cell markers are variably expressed. CD68 is positive in most cases.
T-cell receptor gene rearrangement may be demonstrated with rearrangement studies.
Aggressive cutaneous CD8 positive lymphoma – These do not usually present as single tumours/plaques. CD68 is typically negative and is thought to be a helpful distinguishing feature.
Mycosis fungoides – Clinical presentation is key in distinguishing this entity from tumour stage mycosis fungoides. If the patient has a past history of mycosis fungoides, caution should be take in diagnosing cutaneous small-medium pleomorphic T-cell lymphoma.
T-cell pseudolymphoma – May be similar and many cases may have been called pseudolymphoma in the past. Immunohistochemical studies and T-cell gene rearrangement studies may be helpful to illustrate a clonal population.
Cutaneous small–medium pleomorphic T-cell lymphoma – This entity is composed predominantly of CD4 positive cells. Some authors question whether this is a related entity (given similar benign presentation and course).